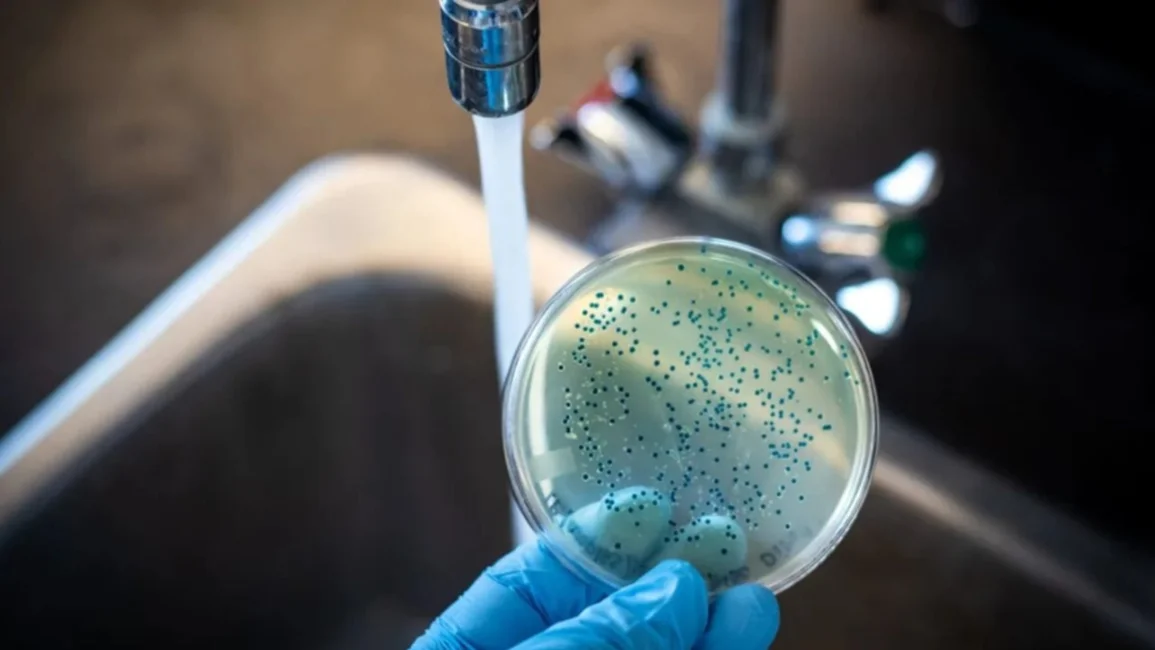

Alerta sanitaria por fiebre tifoidea: qué es y cómo prevenirla
En las últimas semanas, se confirmó un brote de fiebre tifoidea en Ciudadela, partido de Tres de Febrero, provincia de Buenos Aires. Hasta el momento se reportaron 17 casos. Las investigaciones sanitarias identificaron como posible fuente de contagio un sistema de agua de pozo sin control sanitario, compartido por dos edificios.
La fiebre tifoidea es una enfermedad infecciosa causada por la bacteria Salmonella entérica serotipo Typhi. Esta bacteria vive solo en humanos y se transmite por vía fecal-oral: es decir, cuando una persona ingiere agua o alimentos contaminados con materia fecal de una persona infectada. Esto puede ocurrir en contextos de saneamiento deficiente, falta de acceso a agua potable o prácticas de higiene inadecuadas.
Una vez que la bacteria ingresa al organismo, se propaga a través del torrente sanguíneo y puede afectar distintos órganos. El hígado, el bazo y el intestino son algunos de los sistemas más comprometidos. En ausencia de tratamiento, la fiebre tifoidea puede generar complicaciones graves como hemorragias intestinales, perforación del intestino o incluso la muerte.
Síntomas comunes
- Fiebre alta sostenida
- Dolor abdominal
- Náuseas o vómitos
- Estreñimiento o diarrea
- Malestar general y dolor de cabeza
- Erupción en la piel en algunos casos
Prevención
- Usar siempre agua segura (potable o hervida) para beber y cocinar
- Lavar bien frutas y verduras antes de consumirlas
- Lavarse las manos con agua y jabón antes de cocinar, comer y después de ir al baño
- Evitar el consumo de alimentos crudos de dudosa procedencia
- Mantener la higiene en la manipulación de alimentos
Ante síntomas compatibles con esta enfermedad, es fundamental acudir al médico y evitar la automedicación. El tratamiento con antibióticos adecuados puede curar la fiebre tifoidea, pero cuanto antes se diagnostique, menores serán los riesgos.
Recomendamos adherirse a las recomendaciones de las autoridades sanitarias y recordamos la importancia de la prevención para cuidar la salud de la población.